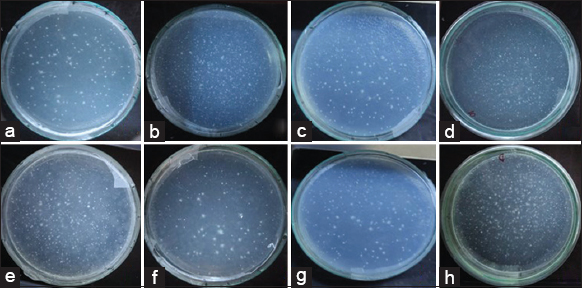

ARTICLE HIGHLIGHTS
Organic solvent and water extracts of S. dulcis and V. cinerea did not induce any genotoxic effect in prokaryotic and eukaryotic cells. Rather, the ethyl acetate extract exerts significant antimutagenic and antigenotoxic effects protecting the DNA.
Desmutagenic actions of the extract components are considered to be the key mechanism of these effects
Genoprotective agents can act as good cancer chemopreventive agents and hence S. dulcis and V. cinerea can be further evaluated for their cancer prevention properties.
1. INTRODUCTION
Cells maintain genomic integrity by various surveillance mechanisms which include DNA damage checkpoints, DNA repair machinery, and mitotic checkpoints. Defects in these mechanisms by the accumulation of damages in the genes which regulate the cell division and tumor suppression often result in tumor initiation and progression [1]. Toxic agents of both endogenous and exogenous origin can exert genotoxicity or genetic damage in the form of DNA strand breakages, chromosomal fragmentation, point mutations, and alterations of gene expression profiles. Chemopreventive drugs generally act as blocking agents which inhibit the interaction of carcinogens or free radicals with DNA thereby preventing tumor initiation or as suppressive agents which interfere with the signal transduction pathways to suppress tumor promotion and progression [2]. The plants used in traditional medicines are the natural sources of bioactive substances that can maintain genomic stability and protect the genes from genotoxic action of xenobiotics by various mechanisms [3]. Thus, exploring novel phytochemicals having genoprotective potentials will be helpful for safe and efficient ways to combat the onset of primary tumor and the recurrence of tumor or secondary tumors which often arises from the genotoxicity of chemotherapeutic medicines.
The plants Scoparia dulcis L. and Vernonia cinerea (L.) Less. are medicinal herbs with ethnomedicinal importance and are found throughout India. Both plants are grown in similar habitats such as forests, agricultural fields, and often on wastelands. V. cinerea (Family: Asteraceae) is considered as one among the ten important medicinal plants known by Dasapushpa in Kerala state of India [4]. In ayurveda, it is used for intermittent fever, boils, blisters, lymphatic filariasis, vaginal discharges, and psychoneurosis [5]. Tribal people of Tamil Nadu state of India use this plant with some other herbs to treat breast tumors [6]. Some studies have reported its anti-inflammatory, antidiabetic, antioxidant, nephroprotective, antimicrobial, and anticancer potentials [7-12]. S. dulcis (Family: Plantaginaceae) has been traditionally used for treating wounds, fever, kidney stones, and urinary disorders in southern parts of India [13-15]. Its antidiabetic, antihyperlipidemic, antiulcer, antioxidant, antisickling, analgesic, and anti-inflammatory activities have been reported in earlier studies [16-20]. The present study was undertaken to evaluate the genoprotective potentials of S. dulcis and V. cinerea against the action of genotoxic agents in prokaryotic and eukaryotic systems.
2. MATERIALS AND METHODS
2.1. Collection of Plant Materials and Extraction
The plants S. dulcis and V. cinerea were collected locally (10°36’39.7”N76°02’10.7”E) and the voucher specimens were identified and kept at Kerala Forest Research Institute, India (Accession numbers are 17,684 and 17,685, respectively). Chopped, shade-dried, and powdered plant materials were extracted separately using ethyl acetate, ethanol, and water in an accelerated solvent extractor (Thermo Scientific, Dionex). Extracts were then concentrated and dried using a vacuum evaporator (Hahnshin Scientific, HS2005 V-N).
2.2. Microorganisms and Cell Lines
The bacterial strains Salmonella typhimurium TA100 (MTCC 1252) used for Ames assay was obtained from Microbial Type Culture Collection and Gene Bank, Institute of Microbial Technology, Chandigarh, India. HepG2 (human hepatic) cell lines were procured from the National Centre for Cell Sciences, Pune, India.
2.3. Ames Assay
Ames Salmonella/microsome assay (bacterial reverse mutation assay) with standard pre-incubation procedure was used to test the mutagenic/antimutagenic potential of plant extracts without S9 activation using S. typhimurium TA100 (base pair substitution) [21]. This assay is widely accepted to detect mutagenic and antimutagenic potential of compounds in pathogenic bacteria. The top agar supplemented with 0.5 mM L-histidine and 0.5 mM D-biotin were prepared and maintained at 45oC. Preincubation mixture containing 100 μL of overnight bacterial culture, 50 μL of mutagen or 50 μL of plant extract at different concentrations, and 500 μL of phosphate buffer was incubated for 20 min at 37oC before mixing with 2 mL of top agar. It was then poured over the surface of glucose minimal agar plates and rotated quickly to spread the top agar evenly on the plate. The plates were then allowed for hardening and incubated at an inverted position in the dark using an incubator at 37°C for 48 h. In post-incubation, the background lawn of the plates was checked for colonies and counted the number of revertant colonies. Negative control without any test chemicals was used to determine spontaneous reversion activity. The positive control (mutagen) employed for the assay was sodium azide (5 μg/plate). For testing antimutagenicity, the standard mutagen was added simultaneously with the plant extracts during pre-incubation. Percentage inhibition rates of mutagenicity were calculated using the formula: Inhibition rate (%) = 1 – (T/M) × 100% where T = No. of revertant in the plate with the mutagen and the plant extract, M= No. of revertant in the positive control. Evaluation of antimutagenicity was done as follows: “strong” >40%, “moderate” between 25% and 40%, and “weak” when the inhibition rate is <25% [22].
2.4. Cytokinesis Block Micronucleus (CBMN) Assay
CBMN assay was conducted with slight modifications according to the protocol of Fenech and OECD guidelines [23,24]. This assay was generally regarded as the comprehensive system to measure DNA damage, cytotoxicity, and cytostasis. The HepG2 cells (2.5 × 105 cells) were seeded in each flask with DMEM and incubated for 24 h. Afterward, the cells were exposed to cyclophosphamide (15 μg/mL) or plant extracts (100 μg/mL) for 3 h (doses are selected based on the cytotoxicity data). For testing antigenotoxic activity, two types of treatment patterns were adopted such as cotreatment where administration of cyclophosphamide simultaneously with the respective samples, and post-treatment (POST) where cyclophosphamide addition, followed by its removal after 3 h which was then followed by the addition of plant extracts for 3 h. Cytochalasin B no later than 20 h was added to cell cultures at a final concentration of 3 μg/mL. Cells were harvested after additional 24 h and were washed in PBS, resuspended (approximately 5 × 106 cells/mL) and spread onto glass slides (20 μL of cell suspension per slide). After air-drying, the cells were fixed twice with methanol/glacial acetic acid (6:1) for 10 min and stained with 5% of Giemsa solution, and mounted with Canadian balsam. Using a light microscope, 1000 binucleated cells were analyzed for each treatment. Three biological replicates for each sample were used with three technical replicates (slides) each and the percentage of micronuclei was calculated. For the analysis of cell cycle progression, 500 cells per treatment were scored for the presence of one, two or more than two nuclei and the cytokinesis block proliferation index (CBPI) was calculated as follows: CBPI = [1N + (2 × 2N) + (3 × >2N)]/TC where 1N is number of cells with one nucleus, 2N with two nuclei, >2N with more than two nuclei and TC is the number of total cells examined. Percentage cytostasis was calculated from CBPI value with the formula % cytostasis = 100 − 100[CBPIt − 1/CBPIc − 1] where t and c are treated and control samples, respectively.
2.5. Data Analysis
All data were expressed as mean ± standard deviation (SD). The values were statistically tested using Student’s t-test in Microsoft Excel. P < 0.05 were considered as significant.
3. RESULTS AND DISCUSSION
Traditional medicinal plants have shown their potential in curing many diseases efficiently and improving the health of people. Since genomic instability has an important role in carcinogenesis, the phytochemicals with the potential to protect DNA from genotoxic events either by prevention or reversal of mutations and chromosomal aberrations can serve as beneficial chemopreventive agents. In this study, the genoprotective potentials of two ayurvedic medicinal plants S. dulcis and V. cinerea were analyzed against the action of genotoxic agents in prokaryotic as well as eukaryotic systems. Experiments conducted to check whether the plant extracts exert mutagenic effects in prokaryotic systems revealed that their treatment alone could not induce mutations in S. typhimurium TA100 bacterial strains even at a concentration of 100 μg/mL when compared with a standard mutagen Sodium azide [Figures 1 and 2]. Further studies were carried out to assess their antimutagenic potential at the same doses in the presence of Sodium Azide which alone has induced 767.67 ± 76.00 revertant colonies. Among the two plants studied, S. dulcis was more efficient in inhibiting the mutations induced by the reference mutagen, Sodium azide. S. dulcis ethyl acetate extract (SDEA) showed stronger antimutagenic potentials (58.32% and 72.95% inhibition at the doses of 50 μg/mL and 100μg/mL, respectively) than ethanol (SDE) and water (SDW) extracts [Table 1]. Ethyl acetate extract of V. cinerea (VCEA) could inhibit the induction of mutations by 57.71% at the higher concentration whereas the lower dose showed only a slight antimutagenic effect [Table 2]. Both ethanol extract (VCE) and water extract (VCW) were not inhibiting the mutagenesis [Figure 3]. Since the reference mutagen used in the experiments was sodium azide (a direct-acting mutagen which does not requires metabolic activation), the possible antimutagenic mechanism exhibited by the ethyl acetate extracts might be the rapid elimination of mutagen from bacteria before their interaction with DNA. This can be done by facilitating the bacterial transmembrane export system to eliminate the mutagens or by blocking the uptake of mutagens into bacteria [25].
 | Figure 1: Mutagenicity assessment of Scoparia dulcis by ames test using Salmonella typhimurium TA100. Figure represents the number of revertant colonies per each treatment in triplicate plates (mean ± SD). Comparisons were made between negative controls with the treated groups separately. The symbol (***) represents statistical significance at P ≤ 0.001. [Click here to view] |
 | Figure 2: Mutagenicity assessment of Vernonia cinerea by Ames test using Salmonella typhimurium TA100. Figure represents the number of revertant colonies per each treatment in triplicate plates (mean ± standard deviation). Comparisons were made between negative controls with the treated groups separately. The symbol (***) represents statistical significance at P ≤ 0.001. [Click here to view] |
Table 1: Antimutagenic effect Scoparia dulcis against the mutagenicity induced by sodium azide to Salmonella typhimurium TA 100.
| Treatment | No. of revertant colonies | Percentage inhibition |
|---|---|---|
| Negative control | 166.33±1.53 | |
| Vehicle control (DMSO) | 164.00±3.61 | |
| PC (NaN3 5 µg/mL) | 767.67±76.00 | - |
| PC+SDEA (50 µg/mL) | 320.00±4.00 | 58.32s |
| PC+SDEA (100 µg/mL) | 207.67±2.52 | 72.95s |
| PC+SDE (50 µg/mL) | 393.67±3.21 | 48.72s |
| PC+SDE (100 µg/mL) | 358.33±3.06 | 53.32s |
| PC+SDW (50 µg/mL) | 559.00±3.61 | 27.18m |
| PC+LSDW (100 µg/mL) | 513.33±12.58 | 33.13m |
Data are presented as the mean±SD. NaN3: Sodium azide. PC: Positive control. NaN3 (5 µg/mL) is the positive control used for TA-100 strain. The symbol (s) represents a strong antimutagenic effect and (m) represents a moderate antimutagenic effect [22]
Table 2: Antimutagenic effect Vernonia cinerea against the mutagenicity induced by Sodium azide to Salmonella typhimurium TA 100.
| Treatment | No. of revertant colonies | Percentage inhibition (%) |
|---|---|---|
| Negative control | 166.33±1.53 | - |
| Vehicle control (DMSO) | 164.00±3.61 | - |
| PC (NaN3 5 µg/mL) | 767.67±76.00 | - |
| PC+VCEA (50 µg/mL) | 606.67±15.28 | 20.97w |
| PC+VCEA (100 µg/mL) | 324.67±9.87 | 57.71s |
| PC+VCE (50 µg/mL) | 520.33±2.08 | 32.22m |
| PC+VCE (100 µg/mL) | 462.67±11.02 | 39.73m |
| PC+VCW (50 µg/mL) | 663.33±3.06 | 13.59w |
| PC+VCW (100 µg/mL) | 618.67±36.75 | 19.41w |
Data are presented as the mean±SD. NaN3: Sodium azide. PC: Positive control. NaN3 (5 µg/mL) is the positive control used for TA-100 strain. The symbol (s) represents a strong antimutagenic effect, (m) represents moderate, and (w) represents a weak antimutagenic effect [22]
| Figure 3: Representative images of his+ revertant colonies after 48 h treatment in glucose minimal plate. (a) Negative control, (b) Positive control (Sodium azide 5 μg/mL), (c) VCEA (100 μg/mL), (d) VCE (100 μg/mL), (e) VCW (100 μg/mL), (f) SDEA (100 μg/mL), (g) SDE (100 μg/mL), (h) SDW (100 μg/mL). [Click here to view] |
Before antigenotoxicity studies, the plant extracts were analyzed for their potential to impart toxicity in the genetic level in the eukaryotic system using in vitro CBMN assay. In this experiment, the appearance of micronuclei in cytokinesis-blocked, binucleated cells was assessed to determine the chromosomal damage. Micronuclei are tiny, extranuclear entities formed by broken chromosomes or whole chromosomes which lag during mitotic division and thus not incorporated in the daughter nuclei [26]. All the extracts from both these plants were found to be non-genotoxic at a concentration of 100 μg/mL in terms of the number of micronucleate cells induced per 1000 binucleated cells [Table 3]. All extracts were tested further for their antigenotoxic potentials against a known genotoxic chemotherapeutic agent, cyclophosphamide, at the concentration of 15 μg/mL which alone induced 231.33 ± 4.16 micronuclei in HepG2 cells. Cyclophosphamide is a chemotherapeutic drug that requires hepatic cytochrome P-450 reaction to become the active metabolite 4-hydroxycyclophosphamide which penetrates the cell and decomposes to form phosphoramide mustard (anticancer metabolite) and acrolein (toxic metabolite). Two treatment protocols such as cotreatment (or simultaneous treatment [SIM]) and POST have been employed to assess the antigenotoxic action of the extracts. Similar to the results from antimutagenic tests in prokaryotes, a strong antigenotoxic effect in this eukaryotic system also was exerted by S. dulcis as compared to V. cinerea [Figure 4]. All extracts of S. dulcis significantly reduced the induction of micronuclei by the cyclophosphamide treatment in both simultaneous and POST-protocols [Table 4]. In the case of V. cinerea, ethyl acetate extract showed a significant reduction in the number of micronuclei in SIM (P ≤ 0.001) than other extracts. Post-treatment of ethanol extract (VCE) did not show significant antimutagenic effects [Table 5 and Figure 5].
 | Figure 4: Antigenotoxicity assessment of plant extracts from Scoparia dulcis and Vernonia cinerea using cytokinesis block micronucleus assay on HepG2 cells. [Click here to view] |
Table 3: Genotoxic effect of plant extracts from Scoparia dulcis and Vernonia cinerea on the induction of micronuclei in HepG2 cells.
| Treatment | No. of MN per 1000 BN cells |
|---|---|
| Vehicle control | 0.33±0.58 |
| CP (15 µg/mL) | 231.33±4.16 |
| SDEA (100 µg/mL) | 4.00±1.00 |
| SDE (100 µg/mL) | 2.00±1.00 |
| SDW (100 µg/mL) | 2.67±0.58 |
| VCEA (100 µg/mL) | 9.00±1.00 |
| VCE (100 µg/mL) | 3.33±0.58 |
| VCW (100 µg/mL) | 1.33±0.58 |
Data are represented as mean±SD. MN: Micronucleus. BN: Binucleated cells
Table 4: Antigenotoxic effect of plant extracts from Scoparia dulcis on the number of micronuclei, cell proliferation, and cytostasis when coadministered with a genotoxic drug cyclophosphamide on HepG2 cells.
| Treatment | No. of MN per 1000 BN cells | CBPI | Cytostasis (%) |
|---|---|---|---|
| Vehicle control | 0.33±0.58 | 1.98 | - |
| CP (15µg/mL) | 231.33±4.16 | 1.69 | 29.7 |
| CP+SDEA (SIM) | 40.00±2.00*** | 1.45 | 55.9 |
| CP+SDEA (POST) | 143.00±11.27*** | 1.43 | 56.13 |
| CP+SDE (SIM) | 94.00±2.00*** | 1.50 | 48.98 |
| CP+SDE (POST) | 187.67±0.58*** | 1.60 | 38.78 |
| CP+SDW (SIM) | 104.33±5.13*** | 1.60 | 38.78 |
| CP+SDW (POST) | 206.33±12.66* | 1.63 | 35.72 |
Data are represented as mean±SD. MN: Micronucleus, BN: Binucleated cells, CBPI: Cytokinesis block proliferation index, CP: Cyclophosphamide (positive control). CP at 15 µg/mL was used in treatment with plant extracts. SIM: Simultaneous treatment, POST: Post-treatment. Comparisons were made between positive controls with the treated groups separately. The symbol (*) represents statistical significance at P≤0.05, (**) represents statistical significance at P≤0.01, and (***) represents statistical significance at P≤0.001
Table 5: Antigenotoxic effect of plant extracts from Vernonia cinerea on the number of micronuclei, cell proliferation, and cytostasis when coadministered with genotoxic drug cyclophosphamide on HepG2 cells.
| Treatment | No. of MN per 1000 BN cells | CBPI | Cytostasis (%) |
|---|---|---|---|
| Vehicle control | 0.33±0.58 | 1.98 | - |
| CP (15µg/mL) | 231.33±4.16 | 1.69 | 29.7 |
| CP+VCEA (SIM) | 58.67±2.08*** | 1.44 | 55.11 |
| CP+VCEA (POST) | 167.67±24.58* | 1.54 | 44.9 |
| CP+VCE (SIM) | 192.67±19.22* | 1.54 | 44.9 |
| CP+VCE (POST) | 206.00±1.00ns | 1.68 | 30.62 |
| CP+VCW (SIM) | 179.67±22.81* | 1.48 | 51.03 |
| CP+VCW (POST) | 188.67±22.59* | 1.66 | 32.66 |
Data are represented as mean±SD. MN: Micronucleus, BN: Binucleated cells, CBPI: Cytokinesis block proliferation index, CP: Cyclophosphamide (positive control). CP at 15 µg/mL was used in treatment with plant extracts. SIM: Simultaneous treatment, POST: Post-treatment. Comparisons were made between positive controls with the treated groups separately. The symbol (*) represents statistical significance at P≤0.05, (**) represents statistical significance at P≤0.01, (***) represents statistical significance at P≤0.001, and (ns) means not significant
 | Figure 5: Representative images of cell types scored in cytokinesis block micronucleus assay. (a) binucleate cell, (b) binucleate cell with micronucleus, (c) mono nucleated cell, and (d) multinucleate cell. [Click here to view] |
There are different mechanisms of action by which phytochemicals protect genes from mutagens or genotoxic agents. It includes desmutagenic action (irreversible binding to the genotoxic agent either extracellularly or intracellularly, chemical inactivation by the modulation of liver metabolic enzymes and also the antioxidant action) and bioantimutagenic action (modulation DNA replication and promoting DNA repair) [27]. In the present study, both modes of actions are seen to be active in various extracts of S. dulcis while the desmutagenic action is a more prominent genoprotective mechanism. Reports on the chemical constituents identified from S. dulcis have revealed the presence of nearly 115 phytochemicals including more diverse groups of flavonoids, diterpenoids, and alkaloids [28]. Many of them possess free radical scavenging properties which may contribute to its antimutagenic activity. The previous studies revealed the presence of flavonoids such as scutellarein, hispidulin, apigenin, and luteolin from S. dulcis [29]. The protective effect of apigenin against the DNA damage induced by cyclophosphamide has been illustrated by its potential for the prevention of metabolic activation of cyclophosphamide or by the ability to scavenge electrophiles/nucleophiles or by enhancing the DNA repair system [30]. In the case of V. cinerea, ethyl acetate extract exhibits more significant genoprotective activity in the SIM pointing toward the desmutagenic action of its phytoconstituents. Our studies on the chemical analysis of this extract have revealed the presence of some sesquiterpenes like beta-caryophyllene and their oxides (data not shown). In a study evaluating the antimutagenicity of beta-caryophyllene using Ames assay on S. typhimurium TA98 and TA100, chemical inactivation of mutagen by this compound was explained as the antimutagenic mechanism [31]. Further, beta-caryophyllene oxide has the potential for modulating liver detoxifying enzymes [32].
Genotoxic action of some anticancer drugs like cyclophosphamide often causes secondary tumor formation in normal cells. Administration of antimutagenic, antigenotoxic, and anticarcinogenic plant-based molecules can be beneficial in these circumstances. CBPI is a useful, accurate, and relevant index for detecting cell cycle delay or cytotoxicity [33]. The observed reductions in the CBPI of ethyl acetate extracts of both plants than other extracts when simultaneously treated with CP from the CP alone treatment reflects its ability to arrest proliferation of cells with damaged genes allowing sufficient time for apoptotic or repair machinery to act further. Phytochemicals having potentials to prevent DNA damage as well as targeted cytotoxic effects on tumor cells can play pivotal roles in the development of new chemotherapeutic drugs or adjuvant to increase the potentials of drugs already in use for cancer treatment [34].
4. CONCLUSION
The genoprotective potentials of S. dulcis V. cinerea against the action of genotoxic agents in prokaryotic and eukaryotic systems were analyzed in this study. Both plants did not show any direct mutagenic effects and in fact could strongly inhibit the mutations/genotoxicity induced by the genotoxic drugs. Desmutagenic actions of the extract components can be explained as the main genoprotective mechanism in all the extract treatments since more inhibition of genotoxicity was obtained in the SIM than in the POST-protocols. Further studies are required in other test systems including animal models to suggest these plants for reducing the occurrence of cancers or as adjuvant, along with the chemotherapeutic agents to lower the risks.
5. ACKNOWLEDGMENT
Author JJ is a recipient of the University Grants Commission-Junior Research Fellowship, Ministry of Human Resource Development, Government of India.
6. AUTHORS’ CONTRIBUTIONS
All authors have read and approved the manuscript. JJ- Conducted experiments and drafted the manuscript and LV- Designed the study and finalized the manuscript.
7. Conflicts of interest
The authors report no financial or any other conflicts of interest in this work.
8. Ethical approvals
This study does not involve experiments on animals or human subjects.
9. DATA AVAILABILITY
The authors confirm that the data supporting the findings of this study are available within the article and/or its supplementary materials.
10. PUBLISHER’S NOTE
The authors confirm that the data supporting the findings of this study are available within the article and/or its supplementary materials.
REFERENCES
1. Yao Y, Dai W. Genomic instability and cancer. J Carcinog Mutagen 2014;5:1000165.
2. Steward WP, Brown K. Cancer chemoprevention:A rapidly evolving field. Br J Cancer 2013;109:1-7. [https://doi.org/10.1038/bjc.2013.280]
3. Koklesova L, Liskova A, Samec M, Qaradakhi T, Zulli A, Smejkal K, et al. Genoprotective activities of plant natural substances in cancer and chemopreventive strategies in the context of 3P medicine. EPMA J 2020;11:261-87. [https://doi.org/10.1007/s13167-020-00210-5]
4. Varghese, KJ, Anila J, Nagalekshmi R, Resiya A, Dasapushpam JS. The traditional uses and the therapeutic potential of ten sacred plants of Kerala state in India. Int J Pharm Sci Res 2010;1:50-9.
5. The Ayurvedic Pharmacopoeia of India. 2nd ed. Ministry of Health and Family Welfare, Department of Indian Systems of Medicine and Homoeopathy. New Delhi:Government of India;2001.
6. Ayyanar M, Ignacimuthu S. Traditional knowledge of Kani tribals in Kouthalai of Tirunelveli hills, Tamil Nadu, India. J Ethnopharmacol 2005;102:246-55. [https://doi.org/10.1016/j.jep.2005.06.020]
7. Kumar PP, Kuttan G. Vernonia cinerea L. Scavenges free radicals and regulates nitric oxide and proinflammatory cytokines profile in carrageenan induced paw edema model. Immunopharmacol Immunotoxicol 2009;31:94-102. [https://doi.org/10.1080/08923970802438391]
8. Haque MA, Abdullah CS, Romana B, Rafique MB, Zia-ulHuda GM, Hossain SF, et al. Evaluation of anti-diarrheal and anti-diabetic activities of the stem, barks and leaves of the plant Vernonia cinerea (Family:Asteraceae). J Basic Appl Pharm Sci 2013;3:69-72.
9. Sreedevi A, Bharathi K, Prasad KV. Effect of Vernonia cinerea aerial parts against cisplatin-induced nephrotoxicity in rats. Pharmacologyonline 2011;2:548-55.
10. Amuthan A, Devi V, Shreedhara CS, Rao V, Jasphin S, Kumar N. Vernonia cinerea regenerates tubular epithelial cells in cisplatin induced nephrotoxicity in cancer bearing mice without affecting antitumor activity. J Tradit Complement Med 2021;11:279-86. [https://doi.org/10.1016/j.jtcme.2020.08.004]
11. Dhanalakshmi P, Priya AJ, Sagadevan E, Lakshmi YS, Manimaran A, Sindhu S, et al. Evaluation of inhibitory effect of Vernonia cinerea L. Leaf extracts on different fungal species. Int J Pharm Pharm Sci 2013;5:414-6.
12. Appadath Beeran A, Maliyakkal N, Rao CM, Udupa N. The enriched fraction of Vernonia cinerea L. Induces apoptosis and inhibits multi-drug resistance transporters in human epithelial cancer cells. J Ethnopharmacol 2014;158:33-42. [https://doi.org/10.1016/j.jep.2014.10.010]
13. Jeeva S, Femila V. Ethnobotanical investigation of Nadars in Atoor village, Kanyakumari District, Tamilnadu, India. Asian Pac J Trop Biomed 2012;2 2 Suppl:S593-600. [https://doi.org/10.1016/S2221-1691(12)60280-9]
14. Xavier TF, Kannan M, Lija L, Auxillia A, Rose AK, Kumar SS. Ethnobotanical study of Kani tribes in Thoduhills of Kerala, South India. J Ethnopharmacol 2014;152:78-90. [https://doi.org/10.1016/j.jep.2013.12.016]
15. Ayyanar M, Ignacimuthu S. Herbal medicines for wound healing among tribal people in Southern India:Ethnobotanical and scientific evidences. Int J Appl Res Nat Prod 2009;2:29-42.
16. Mishra MR, Mishra A, Pradhan DK, Panda AK, Behera RK, Jha S. Antidiabetic and antioxidant activity of Scoparia dulcis Linn. Indian J Pharm Sci 2013;75:610-4.
17. Pari L, Latha M. Antihyperlipidemic effect of Scoparia dulcis (sweet broomweed) in streptozotocin diabetic rats. J Med Food 2006;9:102-7. [https://doi.org/10.1089/jmf.2006.9.102]
18. Girish C, Vineela S, Reddy YN, Rajasekhar KK, Shankarananth V. Antiulcer activity of aqueous extract of leaves of Scoparia dulcis (Linn.) in rats. J Pharm Res 2011;4:2526-8.
19. Patra PK, Debata J, Reddy ES, Samal HB. Antioxidant study of different extracts of Scoparia dulcis. Int J Pharm Pharm Sci 2014;6:600-3.
20. Ahmed R, Ibrahim H, Yakubu MI, Dickson PB. Phytochemical and anti-inflammatory studies on the leaf of Scoparia dulcis Linn. Afr J Biomed Res 2022;25:257-60.
21. Mortelmans K, Zeiger E. The ames salmonella/microsome mutagenicity assay. Mutat Res 2000;455:29-60. [https://doi.org/10.1016/S0027-5107(00)00064-6]
22. Negi PS, Jayaprakasha GK, Jena BS. Antioxidant and antimutagenic activities of pomegranate peel extracts. Food Chem 2003;80:393-7. [https://doi.org/10.1016/S0308-8146(02)00279-0]
23. Fenech M. Cytokinesis-block micronucleus cytome assay. Nat Protoc 2007;2:1084-104. [https://doi.org/10.1038/nprot.2007.77]
24. OECD. Test No. 487:In Vitro Mammalian Cell Micronucleus Test. Paris:OECD Publishing;2010. 23.
25. Ferguson LR, Philpott, M, Karunasinghe N. Dietary cancer and prevention using antimutagens. Toxicology 2004;198:147-59. [https://doi.org/10.1016/j.tox.2004.01.035]
26. Krupina K, Goginashvili A, Cleveland DW. Causes and consequences of micronuclei. Curr Opin Cell Biol 2021;70:91-9. [https://doi.org/10.1016/j.ceb.2021.01.004]
27. Sloczynska K, Powroznik B, Pekala E, Waszkielewicz AM. Antimutagenic compounds and their possible mechanisms of action. J Appl Genet 2014;55:273-85. [https://doi.org/10.1007/s13353-014-0198-9]
28. Jiang Z, Sung J, Wang X, Zhang Y, Wang Y, Zhou H, et al. A review on the phytochemistry and pharmacology of the herb Scoparia dulcis L. for the potential treatment of metabolic syndrome. RSC Adv 2021;11:31235-59. [https://doi.org/10.1039/D1RA05090G]
29. Liu Q, Yang QM, Hu HJ, Yang L, Yang YB, Chou GX, et al. Bioactive diterpenoids and flavonoids from the aerial parts of Scoparia dulcis. J Nat Prod 2014;77:1594-600. [https://doi.org/10.1021/np500150f]
30. Siddique YH, Beg T, Afzal M. Antigenotoxic effect of apigenin against anti-cancerous drugs. Toxicol In Vitro 2008;22:625-31. [https://doi.org/10.1016/j.tiv.2007.12.002]
31. Di Sotto A, Evandri MG, Mazzanti G. Antimutagenic and mutagenic activities of some terpenes in the bacterial reverse mutation assay. Mutat Res 2008;653:130-3. [https://doi.org/10.1016/j.mrgentox.2008.04.004]
32. LnenickováK, SvobodováH, SkálováL, AmbrožM, Novák F, MatouškováP. The impact of sesquiterpenes b-caryophyllene oxide and trans-nerolidol on xenobiotic-metabolizing enzymes in mice in vivo. Xenobiotica 2018;48:1089-97. [https://doi.org/10.1080/00498254.2017.1398359]
33. Lorge E, Hayashi M, Albertini S, Kirkland D. Comparison of different methods for an accurate assessment of cytotoxicity in the in vitro micronucleus test. I. Theoretical aspects. Mutat Res 2008;655:1-3. [https://doi.org/10.1016/j.mrgentox.2008.06.003]
34. Sak K. Chemotherapy and dietary phytochemical agents. Chemother Res Pract 2012;2012:282570. [https://doi.org/10.1155/2012/282570]